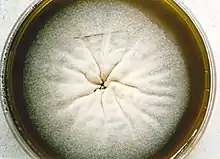
Madurella mycetomatis colony.

| Madurella mycetomatis | |
|---|---|
 | |
| Scientific classification | |
| Kingdom: | |
| Phylum: | |
| Class: | |
| Order: | |
| Family: | |
| Genus: | |
| Species: | M. mycetomatis |
| Binomial name | |
| Madurella mycetomatis | |
| Synonyms | |
| |
Madurella mycetomatis is a fungus primarily reported in Central Africa as a cause of mycetoma in humans. It has been misclassified for many years, but with improvement of molecular techniques, its phylogenetic classification has been established. Many methods exist to identify M. mycetomatis, both in lesions and in culture. Histological examination is especially useful, as it has many unique morphological features. Strain-level differences in response to antifungal agents is informative for treatment and laboratory isolation of cultures.
History
Madurella mycetomatis underwent many name changes. In 1901, Brumpt described the first recorded case of mycosis caused by M. mycetomatis, identifying black granules in association with mycetoma.[2] In 1902, Laveran named the fungus Strepthothrix mycetomi, which he had identified from a mycetoma grain. In 1905, Brumpt corrected its genus to Madurella, in turn changing its name to Madurella mycetomi.[3] The fungus was grown in-vitro by Brault in 1912, so it could be studied in culture.[2] In 1977, the British Medical Research Council changed the name to the currently accepted name, Madurella mycetomatis.[3] With the binomial name determined, M. mycetomatis still remained incorrectly classified in the Pleosporales. This error was corrected in 2015 when M. mycetomatis was placed in the order Sordariales.[4] Maduramycosis or Madura foot, was first described from Madurai, South India, in 1842 by John Gill.[2]
Phylogeny
The genus Madurella contains only two well defined species: M. mycetomatis and M. grisea. Roughly a dozen other species of uncertain validity have been described as genus Madurella based on in vivo similarities and cultural sterility. Although similar, there were important physiological and morphological differences between the two well defined species, leading scientists to doubt their phylogeny. The development of ribosomal sequencing and other molecular techniques, led to the discovery that M. mycetomatis did not share a common ancestor with M. grisea and that M. mycetomatis belonged in the order Sordariales,[3][5] further confirmed by genomic comparison against Chaetomium thermophilum, another member of the Sordariales.[6]
Genotypic variation can help explain geographical distribution of fungi and differences in host symptoms. Restriction endonuclease assay (REA) and random amplification of polymorphic DNA (RAPD) helped characterize the different genotypes of M. mycetomatis, namely 2 genotypic clusters in Africa, and 7 different genotypes from other continents. Further testing with amplified fragment length polymorphism (AFLP) found 3 clusters in Sudan, in contrast to the 2 clusters identified by RAPD, proving AFLP to be a more sensitive method. This showed that M. mycetomatis is not genetically homogenous, and explained the variability in host symptoms affected by the same etiological agent.[3][7]
Physiology and ecology
Madurella mycetomatis has been identified in both soil and anthill samples, growing optimally at 37 ˚C, however can viably grow at up to 40 ˚C.[8][9] This ability to grow at high temperatures is a feature that can be useful in identifying the fungus in culture. The fungus's ability, an inability, to break down various molecules can also be used to confirm its identity. Madurella mycetomatis is amylolytic yet is only weakly proteolytic, and has the ability to assimilate glucose, galactose, lactose and maltose, while unable to assimilate sucrose.[3][8] Potassium nitrate, ammonium sulfate, asparagine and urea can also be used by the fungus.[9] Madurella mycetomatis produces 1,8-dihydroxynapthalene a precursor to melanin – a protein extracellularly attached to proteins.[9] Both molecules are responsible for the characteristic dark grain color. The melanin produced by the fungus has also been identified as a defense mechanism against processes such as hydrolytic enzymes, free radicals, redox buffering, antibodies and complement.[10] The fungus also produces pyomelanin, a brown diffusible pigment.[3]
Growth and morphology
The growth of M. mycetomatis is very slow and can be broken down into three stages. Initially the colony is dome shaped white-yellow or olivaceous brown in color.[9] The mycelium is covered in grey down, giving it a woolly texture. Following the initial stage, brownish aerial mycelia (1 to 5 μm) form and the colony starts producing a diffusible pigment called pyomelanin, and becomes smooth in texture.[3] Older colonies form masses of hyphae called sclerotia or grains. In nutritionally deficient or potato-carrot media, black grains (0.75 to 1 mm in diameter) with undifferentiated polygonal cells can be observed.[8][9]
Grains of M. mycetomatis are hard and brittle, ranging between 0.5 and 1 mm (maximum being 2 mm), with masses from 2 to 4 mm. The grains are oval and often multi-lobed. They are reddish brown to black in color and texturally smooth or ridged.[9][11] The grains are made up of an internal mass of hyphae, 2 to 5 μm in diameter, with terminal cells swelling from 12 – 15 μm (maximum being 30 μm) in diameter.[8] Overall two main types of grains are observed. The most common type is compact or filamentous, where a dark brown cement like amorphous, electron rich substance fills the voids surrounding the hyphal network.[9] The hyphal network differs in growth between the cortical and medullar region, with radial versus multidirectional growth respectively. When stained with hematoxylin and eosin it appears rust-brown in color. In contrast, the second type, vesicular, has a light colored medulla and a brown cortical region filled with hyphae and vesicles 6 to 14 μm in diameter.[12] Often it is difficult to determine the transition point from cortex to medulla. Lesions can have both the filamentous and vesicular type grains at the same time.[3][8]
Although conidiation (conidium), a form of asexual reproduction, in M. mycetomatis is rare, two main types can be described in-vitro. In the first type oval to pyriform conidia, 3 to 5 μm can be observed. The conidia have truncated bases and are on the tips of simple or branched conidiophores. In-vitro, this type of conidiation can be observed in 50% of cultures on soil extract, hay infusion or water agar.[9] When grown on potato carrot agar or cornmeal agar the second type of conidiation is observed. This type is characterized by small spherical conidia (3 μm in diameter) on tapered tips of flask shaped phialides and collarettes.[8][13] On SDA media M. mycetomatis is sterile.[3][9] No sexual stage has been identified for M. mycetomatis.[6]
Mycosis
Madurella mycetomatis is the most common fungus with respect to causing mycetoma in humans,[14] a chronic localized inflammatory disease.[15] Madurella mycetomatis accounts for 70% of mycetoma cases in central Africa, especially common in Sudan.[3] Cases of mycetoma caused by this fungus have also been reported in West Africa, India, Venezuela, Curaçao, Brazil, Peru and Argentina.[11] The mode of entry for etiological agents of mycetoma, such as M. mycetomatis, is trauma, such as; snake bites, knives, splinters, thorns and insect bites. Thus having identified M. mycetomatis in soil and anthill samples substantiates its involvement in mycetoma.[9] Infected hosts from samples in Sudan show variability in clinical symptoms, this corroborates the heterogeneity of M. mycetomatis genotypes.[3][7]
Detection
There are various methods available for the purpose of differentiating fungal species. Histological examination allows for the exploitation of unique morphological features of M. mycetomatis, including but not limited to the unique cement like substance and multi-lobed morphology of the grains.[3][9] Molecular analysis allows for a more sensitive technique to discriminate between morphologically similar species. An internal transcribed spacer (ITS) is amplified by polymerase chain reaction (PCR).[4] Followed by restriction fragment length polymorphism (RFLP) digestion or gene sequencing to obtain the results. The highly variable nature of the ITS sequence between species not only allows for diagnosis, but also the identification of M. mycetomatis in soil samples. ITS has also been cited as the recommended method for isolation of M. mycetomatis.[16] Additionally, molecular analysis lead to the determination that M. mycetomatis did not share a common ancestor with M. grisea, and belonged in the Sordariales class.[3]
Anti-fungal susceptibility
Understanding how a fungus might react to various anti-fungal agents in-vitro can be beneficial when wanting to study or isolate particular organisms in culture. The Clinical & Laboratory Standards Institute (CLSI) M38A methods indicate that conidial suspensions are to be used when testing anti-fungal susceptibility of filamentous fungi. When following these methods for M. mycetomatis, alternative suspensions of hyphal fragments are required, as conidial forms are exceedingly rare. Table 1 summarizes the minimal inhibitory concentrations at 90% (MIC90) for various anti-fungal agents, with specific relation to M. mycetomatis.[3]
| Anti-fungal drug | MIC90 (μg/mL) | MIC50 (μg/mL) | MIC range (μg/mL) |
|---|---|---|---|
| Ketoconazole[17] | 0.25 | 0.06 | ≤0.031–1 |
| Ravuconazole[18] | 0.016 | 0.004 | ≤0.002–0.031 |
| Posaconazole[17] | 0.06 | 0.03 | ≤0.03–0.125 |
| Terbinafine[17] | 16 | 8 | 1–>16 |
| Voriconazole[19] | 0.125 | – | 0.016–1 |
| Isavuconazole[20] | 0.063 | 0.031 | ≤0.016–0.125 |
| Itraconazole[18] | 0.25 | 0.063 | ≤0.016–0.5 |
See also
References
- ↑ Brumpt, E (1905). "Sur le mycétome à grains noirs, maladie produite par une Mucédinée dugenre Madurella n. g.". Comptes Rendus des Séances de la Société de Biologie et de ses Filiales. 58: 997–9.
- 1 2 3 McGinnis, Michael R (2012). Laboratory Handbook of Medical Mycology. London: Academic Press. ISBN 978-0123960146.
- 1 2 3 4 5 6 7 8 9 10 11 12 13 14 Liu, Dongyou (2011). Molecular Detection of Human Fungal Pathogens (1st ed.). Boca Raton, FL: CRC Press. ISBN 978-1439812402.
- 1 2 Samanta, Indranil (2015). Veterinary Mycology. New Delhi: Springer. ISBN 978-8132222798.
- ↑ Heitman, Joseph; Filler, Scott G.; Edwards Jr., John E.; Mitchell, Aaron P. (2006). Molecular Principles of Fungal Pathogens (1st ed.). Washington, DC: American Society Microbiology. ISBN 1555813682.
- 1 2 van de Sande, Wendy W. J. (1 January 2012). "Phylogenetic analysis of the complete mitochondrial genome of Madurella mycetomatis confirms its taxonomic position within the order Sordariales". PLOS ONE. 8 (3): e57774. doi:10.1371/journal.pone.0057774. PMC 3590280. PMID 23483927.
- 1 2 Lopes, Maria M; Freitas, Graciete; Boiron, Patrick (2000). "Potential Utility of Random Amplified Polymorphic DNA (RAPD) and Restriction Endonuclease Assay (REA) as Typing Systems for Madurella mycetomatis". Microbiology. 40 (1): 1–5. doi:10.1007/s002849910001. PMID 10568795. S2CID 22344606.
- 1 2 3 4 5 6 Rippon, John Willard (1988). Medical mycology: the pathogenic fungi and the pathogenic actinomycetes (3rd ed.). Philadelphia, PA: Saunders. ISBN 0721624448.
- 1 2 3 4 5 6 7 8 9 10 11 Murray, Patrick R.; Baron, Ellen Jo (2003). Manual of clinical microbiology (8th ed.). Washington, DC: ASM Press. ISBN 1555817378.
- ↑ Ibrahim, Anahid Izzat; El Hassan, Ahmed Mohammed; Fahal, Ahmed; van de Sande, Wendy W (1 January 2013). "A histopathological exploration of the Madurella mycetomatis grain". PLOS ONE. 8 (3): e57774. Bibcode:2013PLoSO...857774I. doi:10.1371/journal.pone.0057774. PMC 3590280. PMID 23483927.
- 1 2 Baker, Roger Denio (1971). The Pathologic Anatomy of Mycoses: Human Infection with Fungi, Actinomycetes and Algae (1st ed.). Springer Verlag. ISBN 3540051406.
- ↑ Dismukes, William E.; Pappas, Peter G.; Sobel, Jack D. (2003). Clinical Mycology (1st ed.). Oxford University Press. ISBN 0195148096.
- ↑ Gaspari, Anthony A.; Tyring, Stephen K.; Kaplan, Daniel H. (2016). Clinical and Basic Immunodermatology (2nd ed.). Springer. ISBN 978-3319297835.
- ↑ Howard, Dexter H. (2007). Pathogenic fungi in humans and animals (2nd ed.). New York, NY: Dekker. ISBN 978-0824706838.
- ↑ Kradin, Richard L. (2010). Diagnostic Pathology of Infectious Disease. Philadelphia, PA: Saunders Elsevier. ISBN 978-1416034292.
- ↑ "Madurella mycetomatis". Mycology Online. University of Adelaide.
- 1 2 3 Belkum, Alex van; Fahal, Ahmed H.; Sande, Wendy W. J. van de (1 April 2011). "In Vitro Susceptibility of Madurella mycetomatis to Posaconazole and Terbinafine". Antimicrobial Agents and Chemotherapy. 55 (4): 1771–3. doi:10.1128/AAC.01045-10. PMC 3067195. PMID 21263050.
- 1 2 Ahmed, Sarah Abdalla; Kloezen, Wendy; Duncanson, Frederick; Zijlstra, Ed E.; Hoog, G. Sybren de; Fahal, Ahmed H.; Sande, Wendy W. J. van de (19 June 2014). "Madurella mycetomatis Is Highly Susceptible to Ravuconazole". PLOS Negl Trop Dis. 8 (6): e2942. doi:10.1371/journal.pntd.0002942. PMC 4063742. PMID 24945848.
- ↑ van de Sande, Wendy W. J.; Luijendijk, Ad; Ahmed, Abdalla O. A.; Bakker-Woudenberg, Irma A. J. M.; van Belkum, Alex (1 April 2005). "Testing of the in vitro susceptibilities of Madurella mycetomatis to six antifungal agents by using the Sensititre system in comparison with a viability-based 2,3-bis(2-methoxy-4-nitro-5-sulfophenyl)-5- [(phenylamino)carbonyl]-2H-tetrazolium hydroxide (XTT) assay and a modified NCCLS method". Antimicrobial Agents and Chemotherapy. 49 (4): 1364–8. doi:10.1128/AAC.49.4.1364-1368.2005. PMC 1068587. PMID 15793113.
- ↑ Kloezen, Wendy; Meis, Jacques F.; Curfs-Breuker, Ilse; Fahal, Ahmed H.; van de Sande, Wendy W. J. (1 November 2012). "In vitro antifungal activity of isavuconazole against Madurella mycetomatis". Antimicrobial Agents and Chemotherapy. 56 (11): 6054–6. doi:10.1128/AAC.01170-12. PMC 3486573. PMID 22964246.